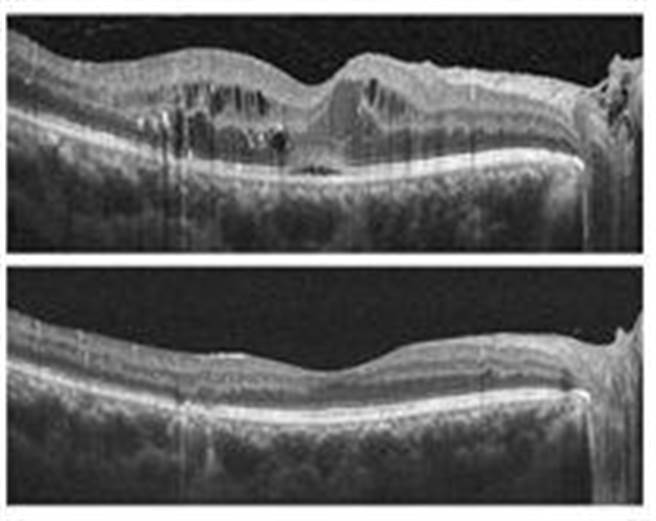
糖尿病黄斑部水肿治疗前（上图）、后（下图）之光学相干断层扫描（OCT）比较。治疗后中间水肿明显减少。（基隆长庚医院提供／徐佑升基隆传真）

基隆一位陈姓职业司机是家中经济支柱,努力工作却很少关心自己血糖控制,已罹患糖尿病20多年。近期因陈先生在监理站视力检查却无法通过,回医院检查才发现两眼已因再度长期「黄斑部水肿」,视力严重受损。
陈先生3年前就因视力下降就医,被诊断为两眼「糖尿病黄斑部水肿」,经两眼各3次眼内药物注射治疗,自觉视力回復便未再回诊追踪。本次又再度復发,经多次眼内药物注射治疗,视力虽然稍有改善,但已大不如前。
基隆长庚医院表示,据国民健康署统计,台湾每10名成人就有1位罹患糖尿病。糖尿病患最常见的併发症就是糖尿病视网膜病变,其中10分之1会併发糖尿病黄斑部水肿,为视力受损最重要的原因之一。
长庚医院说明,黄斑部位于视网膜中心,负责看清事物及顏色分辨的主要区域。而糖尿病会引起视网膜微小血管损伤,导致液体渗漏,当黄斑部组织积聚过多液体,便会膨胀水肿进而影响视力,如不及时治疗,可能造成永久性视力受损。抽菸、高血压、血脂异常等,也都可能导致视网膜微小血管损伤,增加糖尿病黄斑部水肿风险。
基隆长庚医院眼科杨岭医师指出,糖尿病黄斑部水肿的早期症状包括视力模糊或影像变得暗淡,建议糖尿病患应每年定期进行视网膜筛检。平时如有任何视力变化,应立即找眼科医师进一步检查,发现越早治疗效果越好。
目前治疗黄斑部水肿主要使用眼内药物注射方式,可选择抗血管生长因子(Anti-VEGF)或类固醇,各有优缺点。若注射疗效不佳,或水肿不在黄斑部中心区域,也可使用视网膜雷射治疗。如果合併视网膜前膜拉扯,也可考虑玻璃体切除手术。
由于糖尿病黄斑部水肿的注射药物价格较高,有些严重病患甚至需较多次的注射。但好消息是自今年2月开始,健保署已通过增加眼内注射抗血管生长因子药物给付数量,在确认治疗有效的前提下,每眼共可申请针数上限由原来的8针增加到14针,大大减轻患者的经济负担。
杨岭医师表示,有些病患往往治疗几个月后,以为视力已经进步或稳定,就不再回诊追踪治疗,然而病情可能已在不知不觉中再次加重,待多年后再回来时,视力已经受到严重不可逆的损害。
杨岭医师提醒,糖尿病黄斑部水肿是一种严重的眼病,幸而在现代医学技术的帮助下可以被有效地治疗。早期发现、持续治疗、长期追踪、良好的血糖血压控制,是预防视力受损的重要方法。

发表意见
中时新闻网对留言系统使用者发布的文字、图片或檔案保有片面修改或移除的权利。当使用者使用本网站留言服务时,表示已详细阅读并完全了解,且同意配合下述规定:
违反上述规定者,中时新闻网有权删除留言,或者直接封锁帐号!请使用者在发言前,务必先阅读留言板规则,谢谢配合。